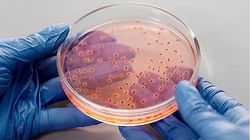

১০ মাস, ২ সপ্তাহ আগে
ব্যাকটেরিয়া
১ বছর, ১ মাস আগে
১ বছর, ৫ মাস আগে
১ বছর, ৭ মাস আগে
১ বছর, ৭ মাস আগে
১ বছর, ১০ মাস আগে
২ বছর, ২ মাস আগে
২ বছর, ৫ মাস আগে
২ বছর, ৬ মাস আগে
২ বছর, ৬ মাস আগে
২ বছর, ৯ মাস আগে
সমকাল
| আমেরিকা / যুক্তরাষ্ট্র
২ বছর, ১০ মাস আগে
২ বছর, ১০ মাস আগে
ডেইলি বাংলাদেশ
| নেপাল
৩ বছর, ১১ মাস আগে
কালের কণ্ঠ
| সিঙ্গাপুর
৪ বছর, ৬ মাস আগে